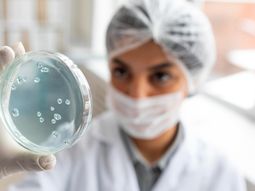
Los científicos argentinos han marcado un hito en la biotecnología global. Los científicos argentinos han marcado un hito en la biotecnología global.

Animales editados genéticamente: ¿Cómo transforman nuestra forma de comer?
Animales diseñados con herramientas genéticas como CRISPR ya forman parte de la oferta alimentaria en países como Japón, Estados Unidos y Brasil.
En los últimos años, la forma en que se producen los alimentos de origen animal ha comenzado a experimentar un cambio profundo. Peces que crecen más rápido, vacas capaces de soportar mejor el calor y cerdos resistentes a enfermedades forman parte de una nueva generación de animales editados genéticamente que ya han sido aprobados para el consumo en países como Japón, Estados Unidos y Brasil, entre otros.
Esta tendencia es posible gracias a la evolución de las tecnologías de edición genética y a la flexibilización de algunos marcos regulatorios que, en varios países, ya no consideran estos organismos como “modificados genéticamente” en el sentido tradicional. Esto significa que pueden llegar al mercado en plazos más breves y, en muchos casos, sin la obligación de llevar etiquetas diferenciadas.
En Argentina, los animales editados genéticamente se han enfocado en la investigación para la mejora de características deportivas y la producción de leche hipoalergénica y con proteínas de leche materna. Aunque no hay animales transgénicos aprobados para consumo comercial, se han creado los primeros caballos editados genéticamente del mundo para mejorar su velocidad. Otras investigaciones incluyen el desarrollo de cerdos cuyos órganos podrían ser compatibles para trasplantes humanos y vacas que puedan tolerar mejor el calor.
De la ingeniería genética a la edición de precisión
La ingeniería genética no es un fenómeno reciente. Desde la década de 1970 se han desarrollado organismos genéticamente modificados (OGM) mediante la transferencia de genes entre especies. Estos transgenes permitían, por ejemplo, que una planta adquiriera resistencia a plagas o herbicidas.
Sin embargo, las primeras técnicas no eran exactas y resultaba difícil predecir en qué parte del genoma se insertaría el nuevo material. Ello obligaba a realizar controles exhaustivos para asegurar que las proteínas generadas no fueran dañinas o alergénicas.
Para regular el avance de estos organismos, muchos países establecieron oficinas y agencias dedicadas a la bioseguridad a partir de la década de 1990.
En las últimas dos décadas, el panorama cambió con la llegada de nuevas herramientas capaces de editar el ADN con gran precisión. Tecnologías como las nucleasas dirigidas permiten modificar o inactivar genes específicos sin necesidad de introducir material de otras especies.
Este proceso se conoce como edición genética y, a diferencia de los OGM tradicionales, no siempre genera organismos con ADN “foráneo”. Esta diferencia ha sido clave para que varios países adopten normativas más flexibles.
La técnica que más ha impulsado esta transformación es CRISPR-Cas9, desarrollada en 2012 por las científicas Emmanuelle Charpentier y Jennifer Doudna, quienes recibieron el Premio Nobel de Química en 2020. CRISPR funciona como unas tijeras moleculares capaces de cortar y modificar el ADN en sitios exactos, con aplicaciones en medicina, agricultura y producción animal.
En 2019, Doudna predijo que los primeros alimentos editados genéticamente estarían disponibles en un plazo de cinco años. Esa expectativa se cumplió mucho antes: en 2021, Japón aprobó la venta de un tomate y un pez editados genéticamente.
Primeros casos en el mercado
El primer animal editado genéticamente comercializado fue un besugo rojo (Pagrus major) en Japón. Mediante la desactivación del gen miostatina, que limita el crecimiento muscular, los ejemplares lograron entre un 20 % y un 60 % más carne sin aumentar el consumo de alimento.
El regulador japonés determinó que este proceso no constituía una modificación genética en el sentido legal, lo que permitió que el producto llegara al mercado tres años después de publicarse los primeros estudios.
A partir de este caso, otras especies se sumaron. Una empresa japonesa ofrece actualmente lenguado oliva y pez globo tigre (fugu) modificados para alterar proteínas que regulan el apetito, de modo que los peces ingieran más alimento y crezcan con mayor rapidez.
En Brasil, se aprobó la edición genética de la tilapia del Nilo (Oreochromis niloticus), a la que también se desactivó el gen de la miostatina. Aunque aún no está disponible en supermercados, los ejemplares presentan una diferencia visible en tamaño respecto a los no editados.
En Estados Unidos y Sudamérica también se autorizaron cerdos editados para eliminar un gen que los hacía susceptibles a enfermedades respiratorias. En paralelo, varios países permiten la producción de ganado con el gen SLICK, que les proporciona un pelaje más corto y mayor tolerancia a climas cálidos.
China, por su parte, concentra una gran inversión estatal en investigación de edición genética animal, aunque todavía no ha aprobado productos para el consumo.
Un cambio en las regulaciones
Uno de los aspectos más relevantes es el cambio en la definición de “organismo modificado genéticamente” en muchos países. En general, si la edición genética no introduce material de otras especies, no se clasifica como OGM.
Esto tiene dos implicancias principales: los productos pueden ingresar más rápido al mercado, ya que no deben atravesar procesos regulatorios tan extensos como los transgénicos tradicionales, y, en muchos casos, no requieren un etiquetado que los diferencie de los alimentos convencionales.
Para los investigadores, esto supone una ventaja significativa. “La edición genética puede acelerar décadas de selección tradicional en cuestión de años”, explican los defensores de la tecnología.
Entre los principales beneficios señalados se destacan:
-Mayor eficiencia en la producción: animales que crecen más rápido o con más masa muscular permiten obtener más carne con los mismos recursos.
-Mejor adaptación al clima: el ganado con el gen SLICK, por ejemplo, tolera mejor altas temperaturas, un factor clave en el contexto del cambio climático.
-Reducción de pérdidas por enfermedades: animales resistentes a virus o bacterias pueden disminuir la necesidad de antibióticos y mejorar la salud general de las poblaciones de cría.
-Contribución a la seguridad alimentaria: la posibilidad de producir más proteínas animales con menos recursos podría ayudar a cubrir la demanda global en crecimiento.
Preguntas abiertas
No obstante, la expansión de esta tecnología también plantea interrogantes. Aunque los científicos destacan la precisión y seguridad de las nuevas herramientas, todavía existen dudas sobre los efectos a largo plazo tanto en la salud humana como en los ecosistemas.
Otro aspecto en debate es la transparencia hacia el consumidor. En ausencia de etiquetas específicas, resulta difícil para las personas saber si el alimento que adquieren proviene de un animal editado genéticamente.
Organizaciones ambientalistas también llaman la atención sobre posibles impactos en la biodiversidad. La introducción de especies editadas en ecosistemas naturales podría alterar dinámicas ecológicas o generar ventajas competitivas frente a especies silvestres.
Los especialistas coinciden en que la investigación continuará ampliándose. Se exploran aplicaciones en aves de corral, mariscos y hasta en la producción de alimentos con propiedades nutricionales mejoradas.
Además, algunos investigadores anticipan una convergencia con el desarrollo de carne cultivada en laboratorio, lo que daría lugar a nuevos productos híbridos que podrían transformar el mercado de proteínas animales.
La aceptación social será un factor determinante. En regiones como la Unión Europea, la regulación sigue siendo más estricta y las actitudes del público hacia los alimentos modificados genéticamente son cautelosas. En cambio, en Asia y América Latina el avance es más rápido y con mayor apertura hacia la innovación.
Un momento decisivo
La edición genética de animales se presenta como una herramienta con gran potencial para enfrentar desafíos globales: alimentar a una población creciente, reducir la huella ambiental de la ganadería y mejorar la resiliencia de los sistemas productivos.
Al mismo tiempo, exige un debate informado sobre sus riesgos, implicancias éticas y efectos a largo plazo. La regulación, la comunicación transparente y la participación ciudadana serán claves para que los beneficios se distribuyan de manera equitativa y para que los consumidores puedan tomar decisiones con información completa.
Lo cierto es que, poco a poco, los animales editados genéticamente están dejando de ser una posibilidad futura para convertirse en una realidad de los mercados alimentarios actuales. Y con ellos, la pregunta que hace unos años parecía lejana comienza a ser cotidiana: ¿qué historia genética hay detrás de los alimentos que consumimos?
Fuente: ABC.net.au con aportes de la Redacción +P.
En esta nota
Te puede interesar